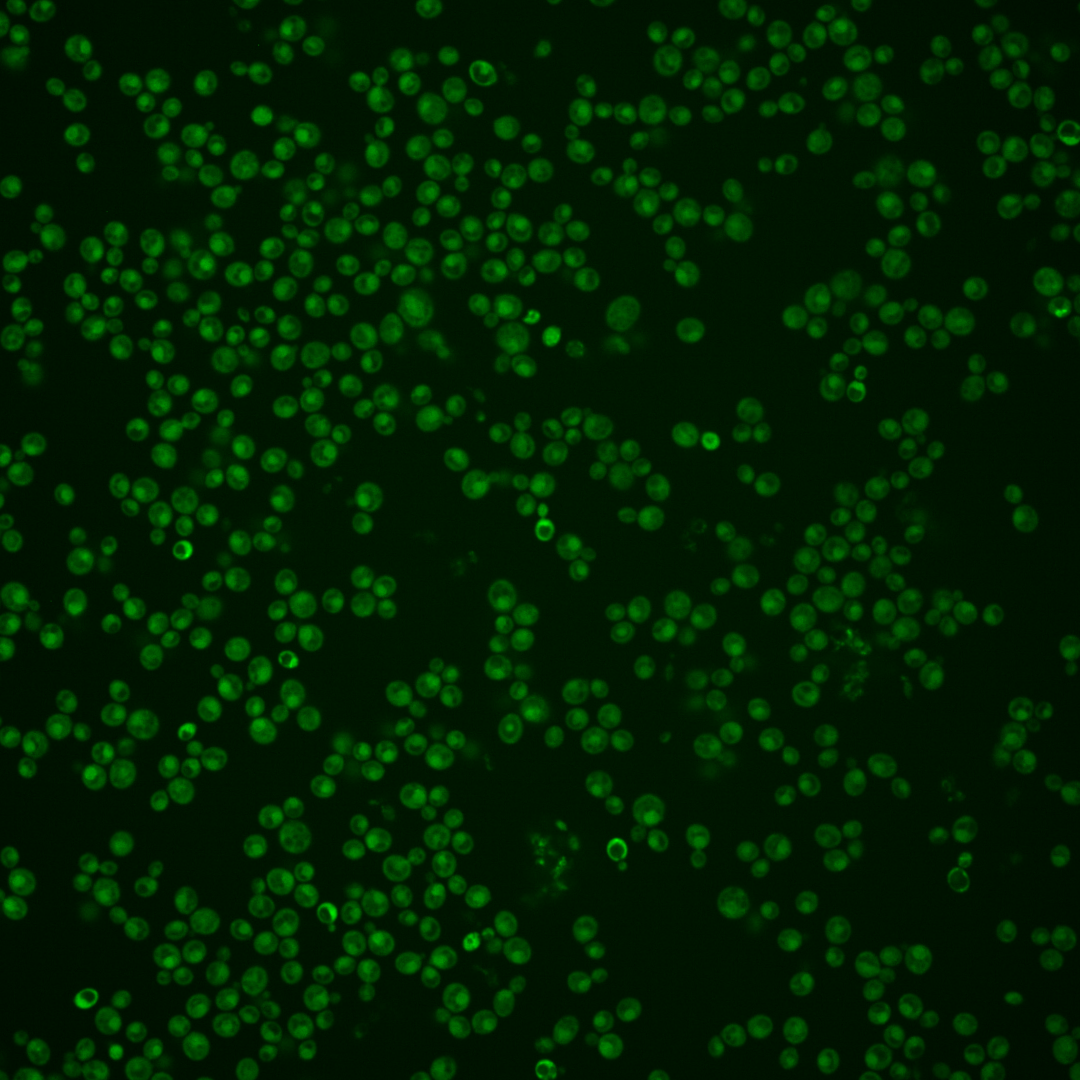
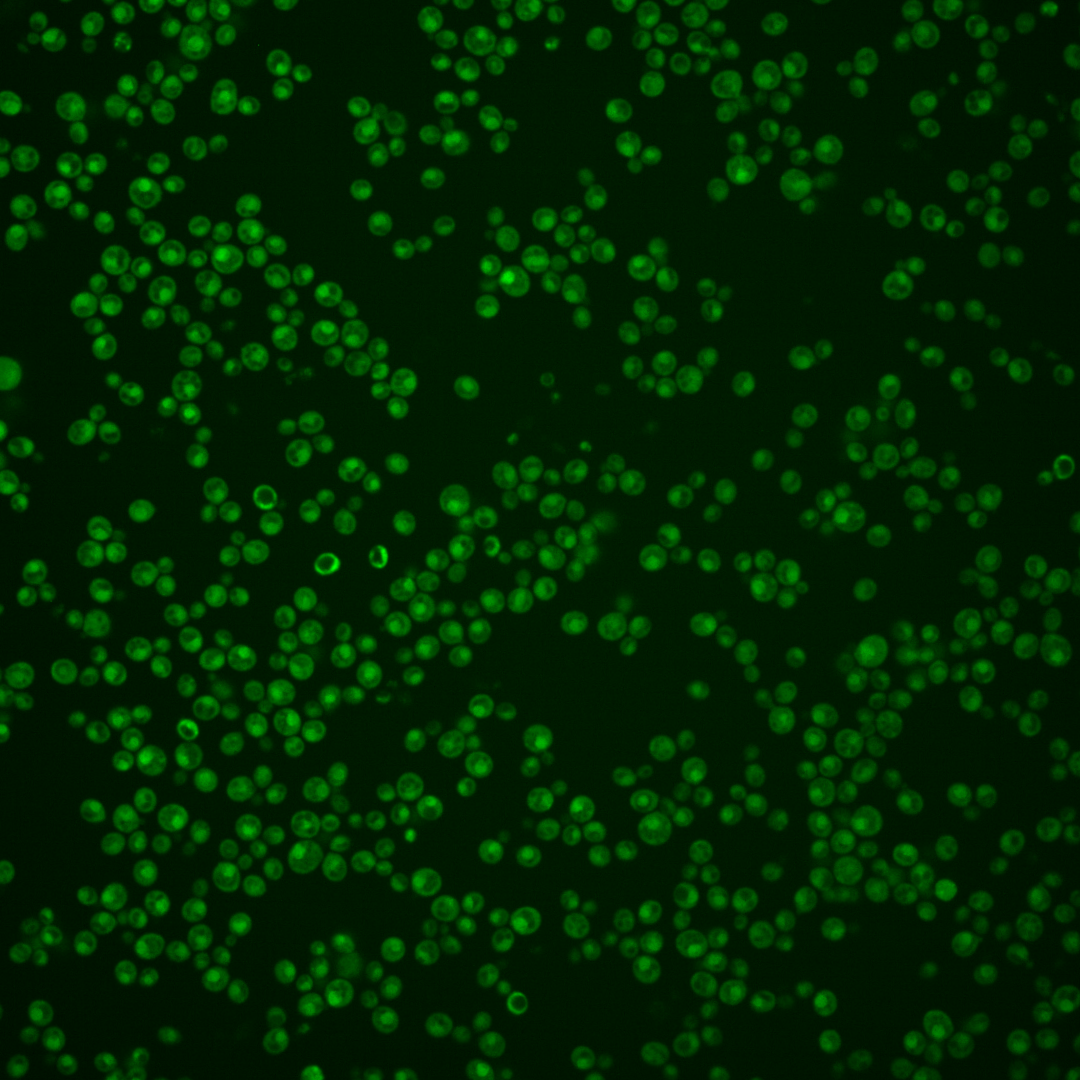
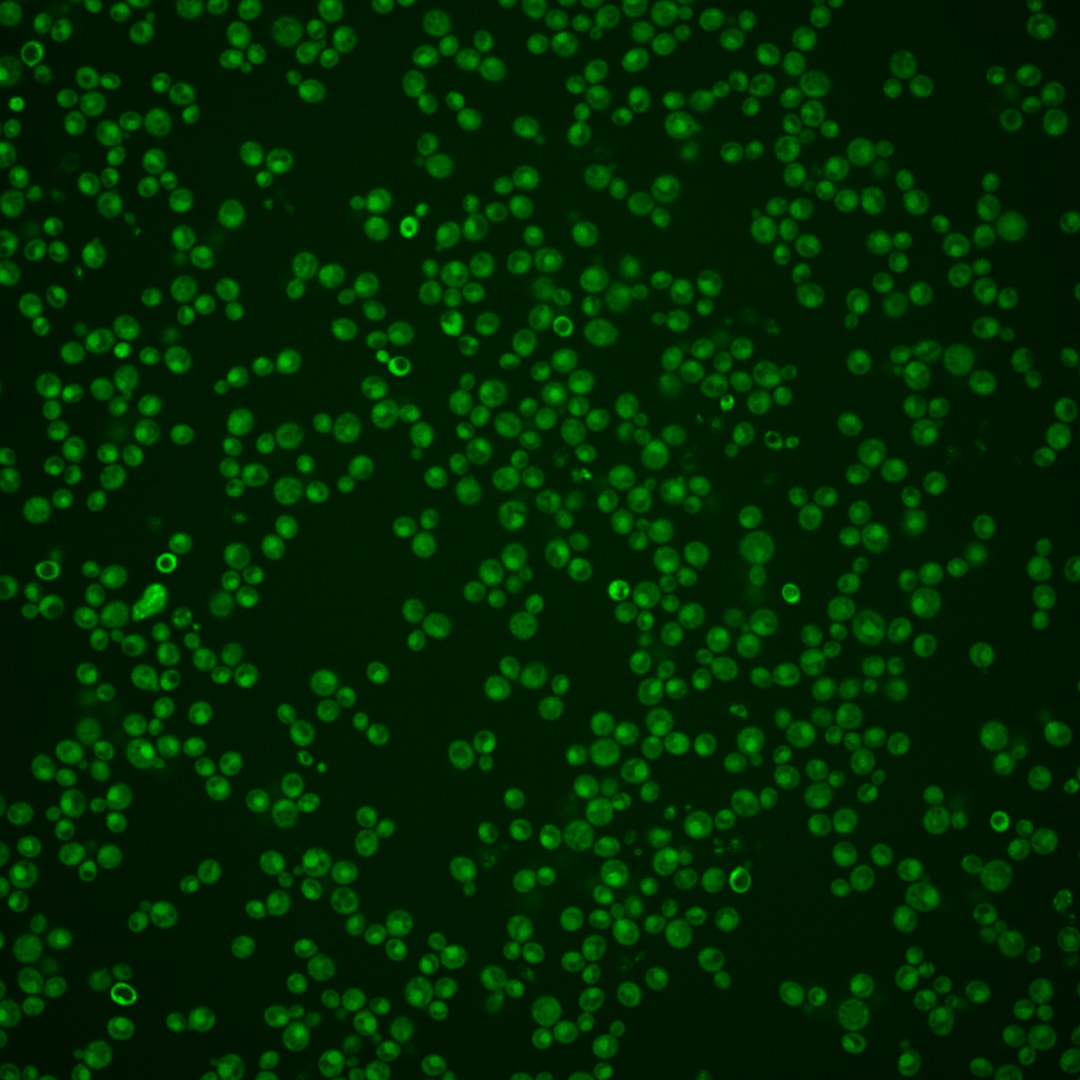
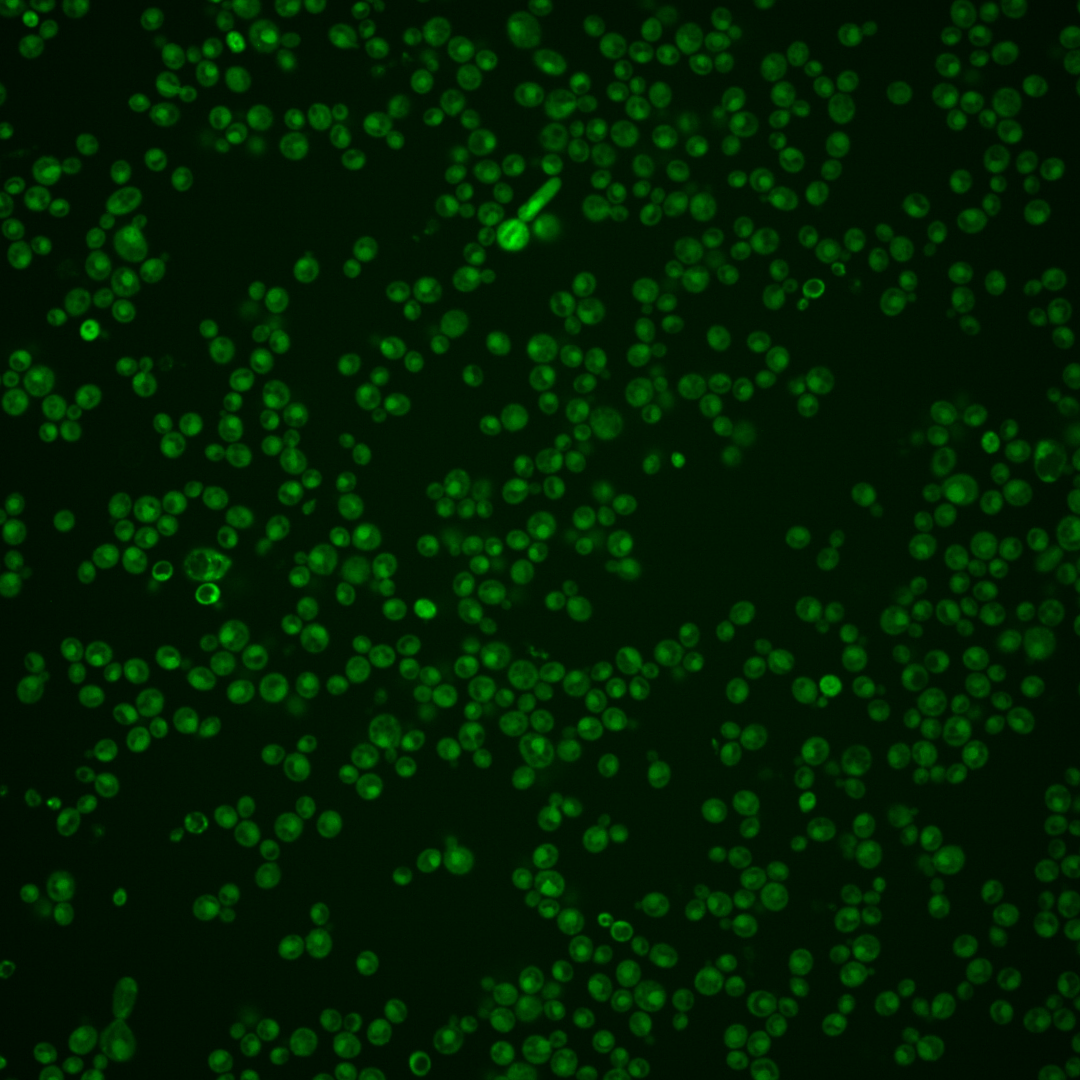

| Standard name | |
|---|---|
| Human Ortholog | |
| Description | Nuclear-enriched ubiquitin-like polyubiquitin-binding protein; required for spindle pole body (SPB) duplication and for transit through the G2/M phase of the cell cycle; involved in proteolysis; interacts with the proteasome; protein abundance increases in response to DNA replication stress |
Micrographs




















































































Sub-cellular Localization
Yeast GFP Assignment
Protein Abundance
Localization Change
External localization resources
| ensLOC | DeepLoc | |||||||||||||||||||||||
|---|---|---|---|---|---|---|---|---|---|---|---|---|---|---|---|---|---|---|---|---|---|---|---|---|
| Localization | WT1 | WT2 | WT3 | RAP60 | RAP140 | RAP220 | RAP300 | RAP380 | RAP460 | RAP540 | RAP620 | RAP700 | HU80 | HU120 | HU160 | rpd3Δ_1 | rpd3Δ_2 | rpd3Δ_3 | WT1 | WT2 | WT3 | AF100 | AF140 | AF180 |
| Cortical Patches | 0 | 0 | 0 | 0 | 0 | 0 | 0 | 1 | 0 | 1 | 0 | 0 | 0 | 0 | 0 | 0 | 0 | 0 | 1 | 1 | 0 | 0 | 2 | 4 |
| Bud | 0 | 0 | 1 | 1 | 0 | 2 | 10 | 2 | 14 | 8 | 9 | 6 | 0 | 0 | 0 | 0 | 0 | 0 | 4 | 7 | 5 | 6 | 17 | 18 |
| Bud Neck | 0 | 0 | 1 | 0 | 0 | 0 | 0 | 0 | 0 | 0 | 0 | 1 | 0 | 0 | 0 | 0 | 0 | 0 | 0 | 1 | 1 | 1 | 4 | 15 |
| Bud Site | 0 | 0 | 0 | 0 | 0 | 0 | 0 | 1 | 1 | 0 | 0 | 1 | 0 | 0 | 0 | 0 | 0 | 0 | – | – | – | – | – | – |
| Cell Periphery | 0 | 0 | 0 | 0 | 1 | 0 | 1 | 3 | 4 | 3 | 0 | 3 | 1 | 1 | 0 | 3 | 6 | 1 | 0 | 0 | 0 | 0 | 0 | 0 |
| Cytoplasm | 157 | 144 | 137 | 121 | 211 | 207 | 178 | 234 | 218 | 222 | 163 | 184 | 174 | 153 | 197 | 127 | 157 | 180 | 161 | 108 | 170 | 193 | 259 | 252 |
| Endoplasmic Reticulum | 3 | 4 | 0 | 1 | 1 | 1 | 0 | 5 | 0 | 5 | 2 | 0 | 2 | 0 | 2 | 10 | 5 | 11 | 19 | 4 | 18 | 4 | 10 | 13 |
| Endosome | 2 | 0 | 5 | 9 | 12 | 3 | 9 | 2 | 2 | 0 | 1 | 2 | 4 | 7 | 12 | 7 | 1 | 2 | 12 | 8 | 8 | 7 | 19 | 13 |
| Golgi | 0 | 0 | 0 | 1 | 0 | 0 | 0 | 0 | 0 | 0 | 0 | 0 | 0 | 1 | 0 | 0 | 4 | 2 | 1 | 3 | 0 | 0 | 1 | 5 |
| Mitochondria | 6 | 0 | 1 | 11 | 14 | 44 | 146 | 59 | 206 | 139 | 178 | 145 | 0 | 0 | 0 | 3 | 3 | 5 | 1 | 0 | 16 | 2 | 5 | 9 |
| Nucleus | 9 | 8 | 12 | 2 | 6 | 32 | 30 | 48 | 34 | 65 | 28 | 52 | 21 | 11 | 13 | 2 | 5 | 10 | 36 | 51 | 35 | 41 | 65 | 56 |
| Nuclear Periphery | 1 | 1 | 0 | 0 | 0 | 0 | 1 | 1 | 0 | 1 | 0 | 0 | 0 | 0 | 0 | 0 | 0 | 0 | 15 | 7 | 14 | 6 | 9 | 8 |
| Nucleolus | 1 | 0 | 0 | 1 | 0 | 0 | 0 | 0 | 0 | 2 | 0 | 1 | 0 | 1 | 0 | 0 | 0 | 0 | 0 | 0 | 0 | 0 | 0 | 2 |
| Peroxisomes | 0 | 0 | 0 | 0 | 0 | 0 | 0 | 0 | 0 | 0 | 0 | 0 | 0 | 0 | 0 | 0 | 0 | 0 | 0 | 0 | 0 | 0 | 0 | 0 |
| SpindlePole | 0 | 0 | 0 | 1 | 0 | 0 | 0 | 0 | 0 | 0 | 0 | 1 | 0 | 1 | 0 | 0 | 0 | 0 | 4 | 2 | 9 | 4 | 9 | 9 |
| Vac/Vac Membrane | 124 | 77 | 172 | 118 | 201 | 144 | 152 | 115 | 126 | 103 | 64 | 131 | 203 | 282 | 277 | 102 | 68 | 93 | 22 | 29 | 43 | 32 | 50 | 45 |
| Unique Cell Count | 266 | 199 | 288 | 230 | 387 | 367 | 419 | 420 | 482 | 464 | 363 | 434 | 344 | 403 | 436 | 211 | 211 | 271 | 292 | 231 | 338 | 306 | 467 | 463 |
| Labelled Cell Count | 303 | 234 | 329 | 266 | 446 | 433 | 527 | 471 | 605 | 549 | 445 | 527 | 405 | 457 | 501 | 254 | 249 | 304 | 292 | 231 | 338 | 306 | 467 | 463 |
Yeast GFP Assignment
Protein Abundance
| Screen | WT1 | WT2 | WT3 | RAP60 | RAP140 | RAP220 | RAP300 | RAP380 | RAP460 | RAP540 | RAP620 | RAP700 | HU80 | HU120 | HU160 | rpd3Δ_1 | rpd3Δ_2 | rpd3Δ_3 | AF100 | AF140 | AF180 |
|---|---|---|---|---|---|---|---|---|---|---|---|---|---|---|---|---|---|---|---|---|---|
| Mean Cell GFP Intensity (1e-4) | 6.6 | 8.7 | 7.5 | 7.2 | 7.6 | 6.0 | 5.4 | 5.8 | 4.9 | 4.9 | 4.6 | 4.9 | 9.3 | 8.7 | 8.8 | 8.5 | 8.6 | 8.1 | 8.3 | 8.1 | 8.8 |
| Std Deviation (1e-4) | 0.8 | 1.2 | 1.2 | 1.2 | 1.4 | 1.1 | 1.3 | 1.3 | 1.0 | 0.9 | 0.9 | 0.9 | 1.5 | 1.5 | 1.6 | 1.8 | 2.1 | 1.8 | 1.9 | 1.4 | 2.0 |
| Intensity Change (Log2) | – | – | – | -0.06 | 0.03 | -0.31 | -0.47 | -0.37 | -0.61 | -0.6 | -0.71 | -0.61 | 0.31 | 0.22 | 0.24 | 0.18 | 0.2 | 0.12 | 0.14 | 0.12 | 0.23 |
Localization Change
| Localization | RAP60 | RAP140 | RAP220 | RAP300 | RAP380 | RAP460 | RAP540 | RAP620 | RAP700 | HU80 | HU120 | HU160 | rpd3Δ_1 | rpd3Δ_2 | rpd3Δ_3 |
|---|---|---|---|---|---|---|---|---|---|---|---|---|---|---|---|
| Cortical Patches | 0 | 0 | 0 | 0 | 0 | 0 | 0 | 0 | 0 | 0 | 0 | 0 | 0 | 0 | 0 |
| Bud | 0 | 0 | 0 | 0 | 0 | 2.5 | 0 | 0 | 0 | 0 | 0 | 0 | 0 | 0 | 0 |
| Bud Neck | 0 | 0 | 0 | 0 | 0 | 0 | 0 | 0 | 0 | 0 | 0 | 0 | 0 | 0 | 0 |
| Bud Site | 0 | 0 | 0 | 0 | 0 | 0 | 0 | 0 | 0 | 0 | 0 | 0 | 0 | 0 | 0 |
| Cell Periphery | 0 | 0 | 0 | 0 | 0 | 0 | 0 | 0 | 0 | 0 | 0 | 0 | 0 | 0 | 0 |
| Cytoplasm | 1.1 | 1.8 | 2.2 | -1.3 | 2.1 | -0.6 | 0.1 | -0.7 | -1.4 | 0.8 | -2.5 | -0.6 | 2.8 | 6.0 | 4.5 |
| Endoplasmic Reticulum | 0 | 0 | 0 | 0 | 0 | 0 | 0 | 0 | 0 | 0 | 0 | 0 | 0 | 0 | 3.5 |
| Endosome | 1.5 | 1.1 | 0 | 0.4 | 0 | 0 | 0 | 0 | 0 | 0 | 0 | 0.9 | 1.1 | 0 | 0 |
| Golgi | 0 | 0 | 0 | 0 | 0 | 0 | 0 | 0 | 0 | 0 | 0 | 0 | 0 | 0 | 0 |
| Mitochondria | 3.3 | 2.9 | 5.8 | 11.1 | 6.4 | 12.8 | 10.1 | 0 | 10.8 | 0 | 0 | 0 | 0 | 0 | 0 |
| Nucleus | -2.3 | -2.1 | 2.3 | 1.7 | 3.4 | 1.6 | 4.3 | 1.9 | 3.6 | 1.1 | -1.0 | -0.9 | -2.2 | -1.1 | -0.3 |
| Nuclear Periphery | 0 | 0 | 0 | 0 | 0 | 0 | 0 | 0 | 0 | 0 | 0 | 0 | 0 | 0 | 0 |
| Nucleolus | 0 | 0 | 0 | 0 | 0 | 0 | 0 | 0 | 0 | 0 | 0 | 0 | 0 | 0 | 0 |
| Peroxisomes | 0 | 0 | 0 | 0 | 0 | 0 | 0 | 0 | 0 | 0 | 0 | 0 | 0 | 0 | 0 |
| SpindlePole | 0 | 0 | 0 | 0 | 0 | 0 | 0 | 0 | 0 | 0 | 0 | 0 | 0 | 0 | 0 |
| Vacuole | -1.9 | -2.0 | -5.2 | -6.1 | -8.6 | -9.3 | -10.4 | -11.1 | -7.9 | -0.2 | 2.8 | 1.0 | -2.5 | -6.1 | -6.0 |
External localization resources
Images






























Protein Concentration and Protein Localization Data
| R1 | R2 | R3 | ||||||||||||||||
|---|---|---|---|---|---|---|---|---|---|---|---|---|---|---|---|---|---|---|
| G1 Pre-START | G1 Post-START | S/G2 | Metaphase | Anaphase | Telophase | G1 Pre-START | G1 Post-START | S/G2 | Metaphase | Anaphase | Telophase | G1 Pre-START | G1 Post-START | S/G2 | Metaphase | Anaphase | Telophase | |
| Concentration | 7.6497 | 9.0024 | 8.1658 | 7.6889 | 6.7235 | 8.0664 | 4.1376 | 6.6423 | 5.7938 | 3.8401 | 4.5192 | 5.2221 | 6.7602 | 7.9435 | 7.2047 | 6.8414 | 6.8742 | 6.9249 |
| Actin | 0.0041 | 0.0014 | 0.0068 | 0.0002 | 0.0056 | 0.0005 | 0.0353 | 0.0078 | 0.0064 | 0.0182 | 0.0831 | 0.0219 | 0.0252 | 0.0008 | 0.0237 | 0.002 | 0.0411 | 0.0014 |
| Bud | 0.0002 | 0.0001 | 0.0001 | 0 | 0.0001 | 0.0001 | 0.0019 | 0.0005 | 0.0002 | 0.0003 | 0.0011 | 0.0011 | 0.0007 | 0.0028 | 0.001 | 0.0001 | 0.0012 | 0.0001 |
| Bud Neck | 0.0018 | 0.0004 | 0.0004 | 0.0003 | 0.0013 | 0.0017 | 0.0057 | 0.0007 | 0.0005 | 0.0018 | 0.0014 | 0.0033 | 0.0056 | 0.0005 | 0.0025 | 0.0004 | 0.0029 | 0.0018 |
| Bud Periphery | 0.0002 | 0.0001 | 0.0001 | 0 | 0.0001 | 0.0001 | 0.002 | 0.0003 | 0.0002 | 0.0005 | 0.0017 | 0.0013 | 0.0013 | 0.0009 | 0.0005 | 0.0001 | 0.0018 | 0.0001 |
| Bud Site | 0.0005 | 0.0004 | 0.0002 | 0.0001 | 0.0001 | 0.0002 | 0.0216 | 0.0025 | 0.0009 | 0.001 | 0.0019 | 0.0018 | 0.0057 | 0.0012 | 0.0011 | 0.0001 | 0.0084 | 0.0001 |
| Cell Periphery | 0.0001 | 0 | 0 | 0 | 0 | 0 | 0.0004 | 0.0001 | 0.0001 | 0.0003 | 0.0003 | 0.0002 | 0.0012 | 0 | 0.0001 | 0 | 0.0004 | 0 |
| Cytoplasm | 0.0671 | 0.1499 | 0.1106 | 0.0398 | 0.0768 | 0.0728 | 0.1274 | 0.311 | 0.1609 | 0.2293 | 0.055 | 0.0663 | 0.0549 | 0.1836 | 0.0579 | 0.0859 | 0.1177 | 0.0697 |
| Cytoplasmic Foci | 0.0048 | 0.0024 | 0.0011 | 0.0002 | 0.0011 | 0.0009 | 0.0296 | 0.015 | 0.0032 | 0.0131 | 0.0211 | 0.0265 | 0.0113 | 0.0004 | 0.003 | 0.0006 | 0.0084 | 0.0013 |
| Eisosomes | 0.0001 | 0 | 0 | 0 | 0 | 0 | 0.0002 | 0 | 0.0001 | 0.0006 | 0.0003 | 0.0001 | 0.0006 | 0 | 0.0002 | 0.0001 | 0.0005 | 0 |
| Endoplasmic Reticulum | 0.0059 | 0.004 | 0.0042 | 0.0018 | 0.006 | 0.0044 | 0.0128 | 0.0051 | 0.0128 | 0.0075 | 0.0144 | 0.006 | 0.0085 | 0.0037 | 0.0054 | 0.0012 | 0.0134 | 0.0024 |
| Endosome | 0.0111 | 0.0047 | 0.0035 | 0.0008 | 0.014 | 0.0052 | 0.0478 | 0.0112 | 0.0322 | 0.0457 | 0.0765 | 0.0645 | 0.0294 | 0.0013 | 0.0097 | 0.0018 | 0.0351 | 0.0045 |
| Golgi | 0.0015 | 0.0008 | 0.0008 | 0 | 0.0013 | 0.0001 | 0.0176 | 0.0016 | 0.0052 | 0.0263 | 0.1296 | 0.033 | 0.0073 | 0.0001 | 0.0027 | 0.0033 | 0.0248 | 0.0019 |
| Lipid Particles | 0.0027 | 0.0002 | 0.0005 | 0 | 0.0014 | 0.0002 | 0.01 | 0.0013 | 0.001 | 0.0207 | 0.0479 | 0.0123 | 0.0057 | 0 | 0.0035 | 0.0154 | 0.0196 | 0.0029 |
| Mitochondria | 0.0016 | 0.0005 | 0.0004 | 0.0003 | 0.0051 | 0.0005 | 0.0117 | 0.0024 | 0.0203 | 0.0778 | 0.0199 | 0.0242 | 0.0104 | 0.0009 | 0.0032 | 0.0211 | 0.0213 | 0.0039 |
| None | 0.0062 | 0.001 | 0.0014 | 0.0005 | 0.0011 | 0.0012 | 0.0124 | 0.0012 | 0.0013 | 0.0083 | 0.0011 | 0.0012 | 0.0023 | 0.0008 | 0.0008 | 0.0004 | 0.0017 | 0.0006 |
| Nuclear Periphery | 0.071 | 0.0427 | 0.0483 | 0.0473 | 0.0859 | 0.0491 | 0.1018 | 0.0614 | 0.0676 | 0.0327 | 0.0648 | 0.0387 | 0.09 | 0.0498 | 0.0461 | 0.0464 | 0.0954 | 0.0531 |
| Nucleolus | 0.0016 | 0.0005 | 0.0005 | 0.0008 | 0.001 | 0.0013 | 0.0014 | 0.0007 | 0.0005 | 0.0005 | 0.0007 | 0.0012 | 0.0009 | 0.0006 | 0.0009 | 0.0007 | 0.0024 | 0.0006 |
| Nucleus | 0.8022 | 0.7833 | 0.8159 | 0.9008 | 0.7878 | 0.8497 | 0.5366 | 0.5656 | 0.6736 | 0.4991 | 0.4604 | 0.6559 | 0.7106 | 0.7445 | 0.8289 | 0.8138 | 0.5712 | 0.839 |
| Peroxisomes | 0.0012 | 0.0014 | 0.0003 | 0 | 0.0005 | 0.0001 | 0.0039 | 0.0019 | 0.001 | 0.0053 | 0.0067 | 0.0048 | 0.0126 | 0.0001 | 0.0016 | 0.0029 | 0.0039 | 0.0003 |
| Punctate Nuclear | 0.0134 | 0.0035 | 0.0029 | 0.0058 | 0.0069 | 0.0089 | 0.0081 | 0.0063 | 0.0025 | 0.0035 | 0.0069 | 0.0279 | 0.0092 | 0.0065 | 0.0036 | 0.0026 | 0.0224 | 0.0122 |
| Vacuole | 0.0019 | 0.0021 | 0.0016 | 0.0008 | 0.0024 | 0.0024 | 0.0101 | 0.0026 | 0.0071 | 0.005 | 0.0028 | 0.0048 | 0.0042 | 0.0012 | 0.0026 | 0.0005 | 0.0038 | 0.0032 |
| Vacuole Periphery | 0.0008 | 0.0004 | 0.0004 | 0.0005 | 0.0015 | 0.0006 | 0.0016 | 0.0009 | 0.0024 | 0.0025 | 0.0024 | 0.0031 | 0.0023 | 0.0003 | 0.001 | 0.0005 | 0.0028 | 0.0007 |
Sequencing Data
| R1 | R2 | |||||||||
|---|---|---|---|---|---|---|---|---|---|---|
| G1 Post-START | S/G2 | Metaphase | Anaphase | Telophase | G1 Post-START | S/G2 | Metaphase | Anaphase | Telophase | |
| Gene Expression | 163.2488 | 166.1543 | 173.5244 | 177.102 | 169.5824 | 190.6791 | 206.4425 | 208.1772 | 231.5825 | 158.9429 |
| Translational Efficiency | 2.6398 | 2.5422 | 2.3608 | 2.2203 | 2.1747 | 2.8028 | 1.9445 | 2.458 | 2.0271 | 2.1763 |
Hit Data
| Dataset | Hit |
|---|---|
| Protein Concentration | ✘ |
| Protein Localization | ✘ |
| Gene Expression | ✘ |
| Translational Efficiency | ✘ |
Endocytosis
| Temp | Actin Patch (Sac6-tdTomato) | Cortical Patch (Sla1-GFP) | Late Endosome (Snf7-GFP) | Vacuole (Vph1-GFP) |
|---|---|---|---|---|
| 37℃ | ||||
| RT |
Cell Cycle Omics
CYCLoPs (Dsk2-GFP)
| Gene / Allele | Actin Patch (Sac6-tdTomato) | Cortical Patch (Sla1-GFP) | Late Endosome (Snf7-GFP) | Vacuole (Sac6-tdTomato) |
|---|
| Gene | Images |
|---|
| Gene | Images |
|---|
Images are not yet available
Images are not yet available